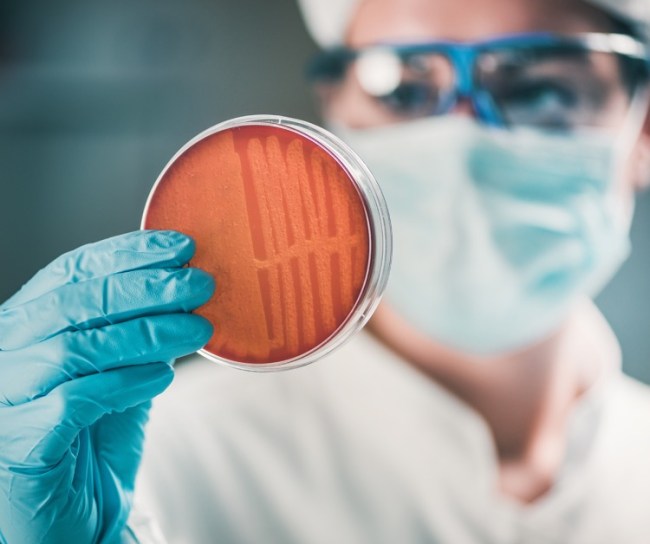

Moștenirea MSD în inovație și activitatea în aria terapeutică antimicrobiană
Respectăm angajamentul nostru de a lupta împotriva bolilor infecțioase de mai bine de un secol

De peste un secol, MSD a contribuit la descoperirea și dezvoltarea de medicamente și vaccinuri noi pentru combaterea bolilor infecțioase. Având în vedere povara tot mai mare a rezistenței antimicrobiene (RAM), ne-am concentrat atenția pe stoparea amenințării tot mai mari a RAM.

1930
Laboratoarele de cercetare MSD au avut un rol principal în dezvoltarea unei sulfonamide, primul antimicrobian sintetic.

1940
În colaborare cu Universitatea Rutgers, am dezvoltat streptomicina, primul antibiotic eficient împotriva tuberculozei. De asemenea, am contribuit la dezvoltarea uneia dintre primele metode pentru producția în masă a penicilinei.

1950 & 1960
Am dezvoltat mai multe metode noi pentru a preveni bolile infecțioase, inclusiv vaccinuri pediatrice.

1970 & 1980
S-a primit aprobarea Administrației pentru Alimente și Medicamente (FDA) din SUA pentru două vaccinuri, precum și pentru trei antibiotice eficiente care tratau mai multe infecții bacteriene.

1990 & 2000
MSD primește aprobarea FDA din SUA pentru două medicamente antifungice, precum și autorizarea a două vaccinuri.
2002
În contextul dezvoltării tot mai rapide a rezistenței la antibiotice între oameni, animale și mediu, am lansat una dintre cele mai mari și mai lungi studii de monitorizare a rezistenței antimicrobiene din lume. Numit Studiul pentru Monitorizarea Tendințelor în Rezistența Antimicrobiană (SMART), acest program permite cercetătorilor să monitorizeze și să identifice tendințele în dezvoltarea RAM.

2010
Am lansat un Program de stewardship antimicrobian (AMS), care sprijină cercetări inițiate de investigatori, evaluate prin arbitraj, susținând implementarea principiilor AMS pe tot globul, cu peste 20% din studii având loc în țări cu venituri mici și medii.

2016
Am creat MSD Exploratory Science Center în Cambridge, Massachusetts, cu accent pe primele etape ale cercetării în biologia de bază a bolilor umane.

2016-2017

2020
MSD, împreună cu un grup de peste 20 de companii biofarmaceutice de top, a lansat Fondul de acțiune împotriva RAM pentru a pune la dispoziția pacienților 2-4 antibiotice noi până la sfârșitul deceniului.

începând cu 2020

În perspectivă
Ca recunoaștere a leadership-ului nostru atât în sănătatea umană, cât și în cea animală, MSD este unul dintre reprezentanții industriei în cadrul One Health Global Leaders Group on Antimicrobian Resistance și pledează pentru o abordare One Health („O singură sănătate”) cu scopul de a se asigura că antibioticele rămân un instrument important în îmbunătățirea și menținerea sănătății umane și animale.
RO-NON-01000/ 12 2023, EXP 12 2025